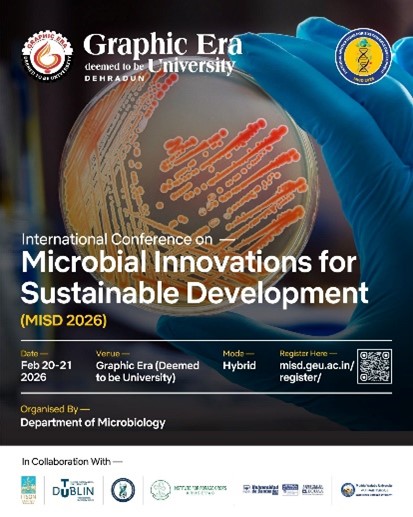

What We Do
Activities
Explore our resources, events, and milestones.
Resources
Promote cutting-edge research in microbiology, biotechnology, and related life sciences.
Events & Outreach
Conferences, workshops, seminars, and community outreach programs.
History & Milestones
Key achievements and milestones in our society’s journey.
Publications
Research papers, articles, and scientific publications by our members.
Upcoming Events
Conference
Coming Soon….
Seminars
Coming Soon….
Workshops
Coming Soon….
Training
Coming Soon….
Archived Events
Conference

International Conference
Regenerative and Resilient: Shaping the Future of Agriculture through Sustainability (RRSFAS)
24 – 25 April 2026
Organized by
Maya Devi University & Uttarakhand State Council for Science and Technology, (UCOST) Dehradun.
In association with ICAR–Indian Institute of Soil and Water Conservation, Dehradun & Department of Agriculture, Government of Uttarakhand
Venue : Maya Devi University, Selaqui, Dehradun, India – Hybrid
International Conference

International Conference
Recent Advances in Phytochemical Research for Sustainable Development (RAPRSD-2026)
1 – 2 April 2026
Organized by
Centre for Phytochemical Research, Sharda University, Greater Noida, India
Sponsor Award by PMMITA Society:
PMMITAS Young Researcher Award
PMMITAS Best Publication Award
International Conference

National Conference
Non-Communicable Diseases: Translational Innovations, AI Integration and Therapeutic Applications (NDTAT’26)
13 March 2026 Organized By Department of Pharmaceutical Technology, Paavai Engineering College, India
Sponsor Award by PMMITA Society:
– Outstanding Therapeutic Applications Award
– NextGen Health Care Award
Registration link: https://forms.gle/TgsF3k87nWCCXE61A
National Conference
International Conference
Microbial Innovations for Sustainable Development (MISD) 2026
20-21 February 2026 in Hybrid Mode at Department of Microbiology, Graphic Era (Deemed to be University), Dehradun, Uttarakhand, India
https://misd.geu.ac.in/
International Conference

International Conference
Translational Research, Innovation & Bio-Entrepreneurship 2026 (TRIBE-2026)
30–31 January 2026 at the BIRAC E-YUVA Centre, Department of Biotechnology, GIET University, Odisha, India
International Conference

International Conference
Science & Technological Innovations in Life Sciences, Agriculture and Food & Nutrition- ICALF 2026
19–20 January 2026 at Swami Vivekananda University (SVU), Barrackpore, West Bengal, India
International Conference
Seminars

National Training Session And Bootcamp
IPR Emerging Trends and Career Opportunities in Biotechnology
25 February 2026 (IST 6:30 PM) in Hybrid Mode at Tech Mindsparc Innovations (an AICTE-approved and ISO-certified organization), India
https://mindsparc.in/
Seminar
Workshops
Coming Soon….
Training
Coming Soon….
For Events and Outreach Program Collaborations with PMMITAS
Reach us at:
President, PMMITAS
Phone: +91-6370605142
Treasurer, PMMITAS
Phone: +91-8437525941
Email: pmmitasociety@gmail.com, pmmitasociety@mitas.in















